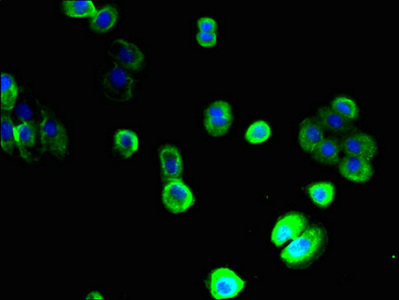

-
中文名稱:SLC22A9兔多克隆抗體
-
貨號:CSB-PA811607LA01HU
-
規格:¥440
-
圖片:
-
其他:
產品詳情
-
產品名稱:Rabbit anti-Homo sapiens (Human) SLC22A9 Polyclonal antibody
-
Uniprot No.:
-
基因名:SLC22A9
-
別名:SLC22A9 antibody; hOAT4 antibody; OAT7 antibody; UST3 antibody; Solute carrier family 22 member 9 antibody; Organic anion transporter 7 antibody
-
宿主:Rabbit
-
反應種屬:Human
-
免疫原:Recombinant Human Solute carrier family 22 member 9 protein (45-143AA)
-
免疫原種屬:Homo sapiens (Human)
-
標記方式:Non-conjugated
本頁面中的產品,SLC22A9 Antibody (CSB-PA811607LA01HU),的標記方式是Non-conjugated。對于SLC22A9 Antibody,我們還提供其他標記。見下表:
-
克隆類型:Polyclonal
-
抗體亞型:IgG
-
純化方式:>95%, Protein G purified
-
濃度:It differs from different batches. Please contact us to confirm it.
-
保存緩沖液:Preservative: 0.03% Proclin 300
Constituents: 50% Glycerol, 0.01M PBS, PH 7.4 -
產品提供形式:Liquid
-
應用范圍:ELISA, IHC, IF
-
推薦稀釋比:
Application Recommended Dilution IHC 1:20-1:200 IF 1:50-1:200 -
Protocols:
-
儲存條件:Upon receipt, store at -20°C or -80°C. Avoid repeated freeze.
-
貨期:Basically, we can dispatch the products out in 1-3 working days after receiving your orders. Delivery time maybe differs from different purchasing way or location, please kindly consult your local distributors for specific delivery time.
-
用途:For Research Use Only. Not for use in diagnostic or therapeutic procedures.
相關產品
靶點詳情
-
功能:Sodium-independent organic anion transporter which exhibits high specificity for sulfated conjugates of xenobiotics and steroid hormones. It is also specifically activated by 3 to 5 carbons-containing short-chain fatty acids/SCFAs, including propionate, butyrate and valerate. May operate the exchange of sulfated organic components against short-chain fatty acids/SCFAs at the sinusoidal membrane of hepatocytes.
-
基因功能參考文獻:
- two human organic anion transporters OAT2 and OAT7 activities were assessed. PMID: 28945155
- Pravastatin is the first identified OAT7 drug substrate. Substantial inter-individual variability in hepatic OAT7 expression, majorly driven by HNF4alpha, may contribute to pravastatin drug disposition and might affect response. PMID: 26239079
- uptake of steroid sulfates by isolated trophoblasts is mediated by OATP-B and OAT-4 suggesting a physiological role of both carrier proteins in placental uptake of fetal-derived steroid sulfates. PMID: 12409283
- Both progesterone and activation of PKC inhibited hOAT4 activity through redistribution of the transporter from cell surface to the intracellular compartments. PMID: 17341544
- OAT7 is the first liver-specific transporter among members of the organic anion transporters of SLC22 family. PMID: 17393504
- The data provide a model for the concerted action of OAT1 mediating apical secretion of glutarate derivatives from proximal tubule cells PMID: 18365245
- The regulatory single nucleotide polymorphism (SNP) of OAT4 found in the promoter region of nephrectomized patients is unlikely to influence mRNA expression or promoter activity of OAT4. PMID: 18414781
- Review summarizes current knowledge on the functional and phenotypic consequences of genetic variation in intestinally, hepatically and renally expressed members of solute carrier family (SLC22) member 9. PMID: 18466105
- Functional differences in steroid uptake of SLC22A9 and SLC02B1 in human placenta are reported. PMID: 18501590
- Human organic anion transporter hOAT4 is a transporter of perfluorooctanoic acid. PMID: 19371258
顯示更多
收起更多
-
亞細胞定位:Basolateral cell membrane; Multi-pass membrane protein. Note=Enriched at the sinusoidal part of the plasma membrane.
-
蛋白家族:Major facilitator (TC 2.A.1) superfamily, Organic cation transporter (TC 2.A.1.19) family
-
組織特異性:Specifically expressed in liver by hepatocytes (at protein level).
-
數據庫鏈接:
Most popular with customers
-
-
YWHAB Recombinant Monoclonal Antibody
Applications: ELISA, WB, IHC, IF, FC
Species Reactivity: Human, Mouse, Rat
-
Phospho-YAP1 (S127) Recombinant Monoclonal Antibody
Applications: ELISA, WB, IHC
Species Reactivity: Human
-
-
-
-
-